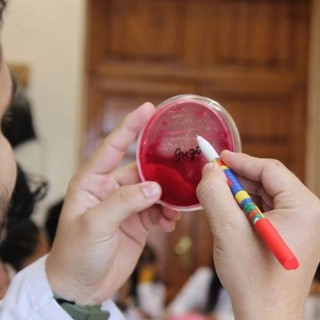

Данная организация находится в статусе «Архивная» — это означает, что с последнего её посещения под управляющим аккаунтом прошло более 365 дней.
Как такое могло произойти?
- был утерян доступ (логин/пароль) к управляющему аккаунту;
- был утерян доступ к привязанной почте;
- сотрудник вашей организации, который добавил организацию, более не работает в вашей организации.
В соответствии с правилами SciNetwork такие организации переводятся в статус «Архивная», а на её странице располагается данный информационный блок, чтобы дать возможность представителям организации восстановить доступ.
Университет открыт на базе переехавшего на тверскую землю Ленинградского стоматологического института. В настоящее время в Тверском ГМУ реализуются 5 программ специалитета, 37 программам ординатуры, 26 программам аспирантуры, 79 программ профессиональной переподготовки и повышения квалификации. В университете обучаются более 5000 тыс. человек, из которых около 1500 человек - иностранные граждане из 47 стран мира.
В Университете с 01.09.2023 открыта Гимназия, в которой реализуются образовательные программы основного общего и среднего общего образования.
В университете организованы курсы по подготовке к ЕГЭ, в том числе в дистанционном формате.
В 2024 году объявлен набор на обучение по программе подготовки специалистов среднего звена по специальности 33.02.01 Фармация.
Сводная информация
- Полное название
-
ФЕДЕРАЛЬНОЕ ГОСУДАРСТВЕННОЕ БЮДЖЕТНОЕ ОБРАЗОВАТЕЛЬНОЕ УЧРЕЖДЕНИЕ ВЫСШЕГО ОБРАЗОВАНИЯ "ТВЕРСКОЙ ГОСУДАРСТВЕННЫЙ МЕДИЦИНСКИЙ УНИВЕРСИТЕТ" МИНИСТЕРСТВА ЗДРАВООХРАНЕНИЯ РОССИЙСКОЙ ФЕДЕРАЦИИ—
- Короткое название
-
ФГБОУ ВО ТВЕРСКОЙ ГМУ МИНЗДРАВА РОССИИ—
- Тип
- Высшее учебное заведение